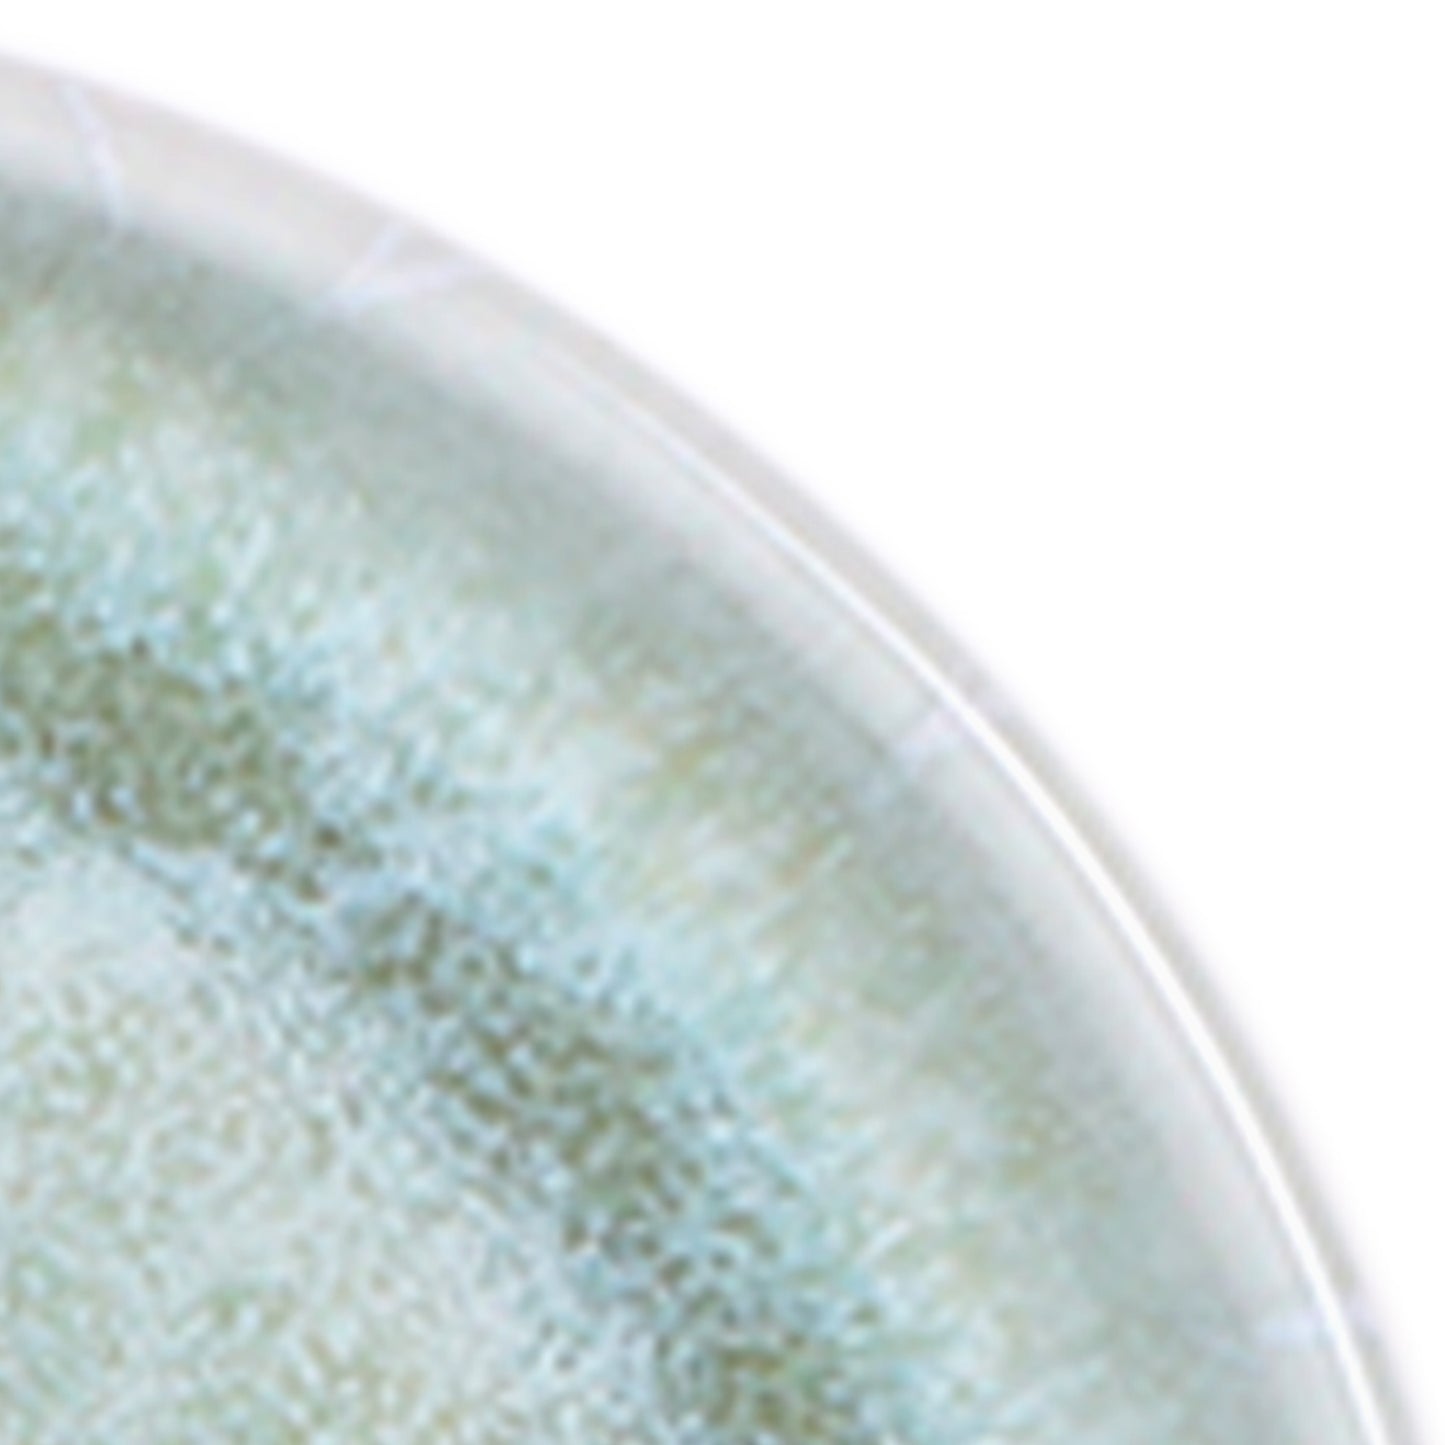

1
/
of
7
Melamine Round Plate - Sea Moss
Melamine Round Plate - Sea Moss
SKU: B190053-SM
Regular price
$4.73
Regular price
Sale price
$4.73
Unit price
/
per
Shipping calculated at checkout.
Couldn't load pickup availability
The modern coupe presentation accompanied with artistic designs demands attention. Our coupe plates and bowls are fresh, daring and radiant. Available in four colors: White, Indigo, Sea-moss, and Cobalt Design.
- 100% Premium Melamine
- Commercial Dishwasher Safe
- Break and Chip Resistant
- Great for Casual and Fine Dining
Features
BPA Free, Break Resistant & Dishwasher Safe
Literature
Collections
Share







| Length | 5.25 in | 13.34 cm |
|---|---|---|
| Width | 5.25 in | 13.34 cm |
| Height | 0.88 in | 2.22 cm |